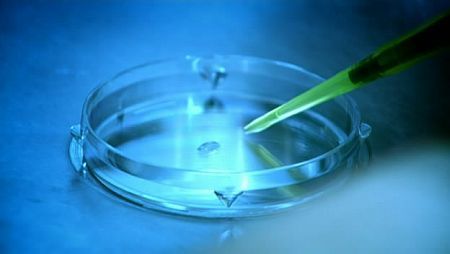

My Writings. My Thoughts.
Root of All Evil?
Em » 12 de out. de 2009 //
In »
Documentário

É esse o título pontiagudo do documentário feito para TV, escrito e apresentado por Richard Dawkins, onde ele argumenta que o mundo seria melhor sem religiões. Foi exibido a primeira vez em Janeiro de 2006, na Inglaterra. São dois didáticos episódios de 45 minutos; o primeiro The God Delusion, onde ele explora o processo de não-raciocínio que chamamos, eufemisticamente, de fé. Um processo divisivo e perigoso, que vai de encontro ao real entendimento do mundo. O segundo, The virus of faith, é onde a coisa engrossa. Dawkins explora a propagação da fé e a precoce instalação de dogmas em crianças e o efeito de rótulo, alienação e segregação causado pela educação religiosa. Neste ambiente o documentário esboça o conceito de Memes. O conceito de Memes proposto por Dawkins soa, a primeira leitura, absurdo e tão improvável quanto a virgem de guadalupe. Mas é uma hipótese respeitada, que estuda o comportamento das idéias, aproximando a evolução cultural da evolução biológica. Os dois episódios são amplamente detalhados nos livros The God Delusion e The Selfish Gene.
vagalumerosa.wordpress.com*
vagalumerosa.wordpress.com*

ID: 281
Título Original: Root of All Evil?
Gênero: Documentário,
Direção: Russell Barnes
Produção:
Tempo de Duração: 90 min
Ano de Lançamento (UK): 2006
Elenco
Yousef Al-Khattab, Richard Dawkins, Ted Haggard, Richard Harries
Classificação:
NC

Já assistiu este filme? Então comente abaixo e informe se presta ou não!
My photos. Now you know me.
My lifestream. Stay updated with me.
Melhor visualizado com Firefox ou Chrome
Acesse a central de informações.
My videos. Featured videos.
Arquivo do blog
Veja os outros filmes
Acesse a central de informações.



.jpg)












Postar um comentário